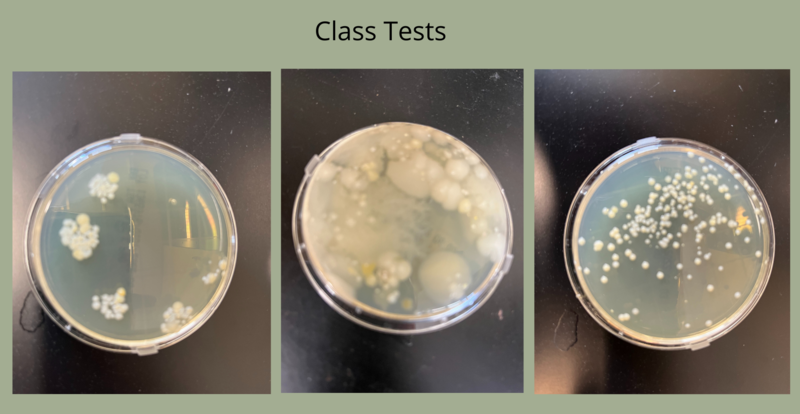

Last week, high school students in Mrs. Wolfe’s Introduction to Microbiology class, as well as Biology class, hosted a guest speaker from the Rensselaer-based company Regeneron. According to their website, Regeneron is a leading biotechnology company that invents life-transforming medicines for people with serious diseases. This visit was meant to give students direct access to real-world applications of microbes and career exploration.
Mike Young is a Senior Manager in Quality Assurance in Microbiology for Regeneron and came to speak with students about what their company does, the types of research they specialize in, and how this relates to the microbiology field. They also reviewed aseptic techniques and different career opportunities that exist within the microbiology field. Students then got to get hands-on and took samples of surfaces around their classroom on Petri dishes. Later, they examined the dishes to see what types of microorganisms are in their environment.
“This was an amazing opportunity for our students to gain insight directly from someone that is in a career based off of what they are learning,” said High School Science teacher Mrs. Wolfe. “They were able to ask questions about realistic applications of microbiology and gain a better understanding of what a career might look like in this field.”
Students can take Introduction to Microbiology in their junior or senior year. It introduces the basic principles of microbiology, examining the microbes that inhabit our planet and their effect on the biosphere. Students analyze the influence of microbiology and 21st-century challenges and opportunities that arise from our changing relationship with microbes.
Another great opportunity to connect the outside world of careers and education with our RCS students!